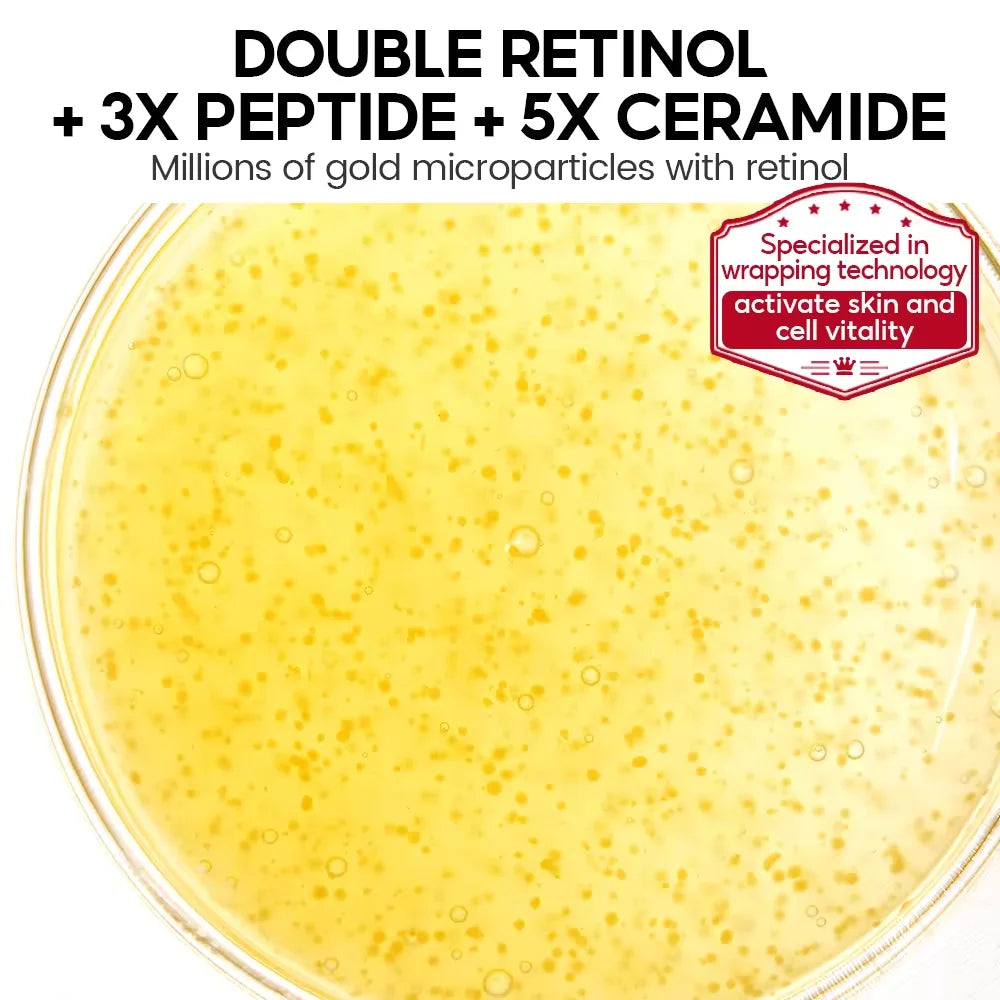
VIBRANT GLAMOUR  PRO+ Retinol Face Serum Upgrade 3% Retinol+3X Peptide+5X Ceramide Repair Skin Firming Collagen Anti-Aging

1
/
of
25
VIBRANT GLAMOUR PRO+ Retinol Face Serum Upgrade 3% Retinol+3X Peptide+5X Ceramide Repair Skin Firming Collagen Anti-Aging
VIBRANT GLAMOUR PRO+ Retinol Face Serum Upgrade 3% Retinol+3X Peptide+5X Ceramide Repair Skin Firming Collagen Anti-Aging
Regular price
$37.46 CAD
Regular price
$37.46 CAD
Sale price
$37.46 CAD
Unit price
/
per
Couldn't load pickup availability
Share
SPECIFICATIONS
Brand Name: VIBRANT GLAMOUR
Country/Region of Manufacture: CHINA
Feature: Anti-Aging
Formulation: Liquid
Gender: Unisex
Item Type: face serum
Number of Pieces: One Unit
Origin: Mainland China